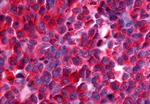
NEK9 Antibody in Immunohistochemistry (Paraffin) (IHC (P))
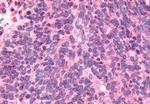
NEK9 Antibody in Immunohistochemistry (Paraffin) (IHC (P))
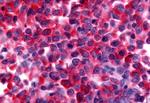
NEK9 Antibody in Immunohistochemistry (Paraffin) (IHC (P))

Search
Invitrogen
NEK9 Polyclonal Antibody
{{$productOrderCtrl.translations['antibody.pdp.commerceCard.promotion.promotions']}}
{{$productOrderCtrl.translations['antibody.pdp.commerceCard.promotion.viewpromo']}}
{{$productOrderCtrl.translations['antibody.pdp.commerceCard.promotion.promocode']}}: {{promo.promoCode}} {{promo.promoTitle}} {{promo.promoDescription}}. {{$productOrderCtrl.translations['antibody.pdp.commerceCard.promotion.learnmore']}}
产品信息
PA5-33962
种属反应
宿主/亚型
分类
类型
抗原
偶联物
形式
浓度
规格
纯化类型
保存液
内含物
保存条件
运输条件
RRID
产品详细信息
Percent identity with other species by BLAST analysis: Human, Gorilla, Gibbon (100%) Monkey, Marmoset (89%).
靶标信息
NEK9, a NEK type protein kinase, regulates chromosome alignment and segregation in mitosis. The protein has a N-terminal NIMA-like catalytic domain, a central domain with homology to the guanine nucleotide exchange factor for the GTPase Ran (RCC1), and a C-terminal coiled-coil domain. It is phosphorylated by active p34(Cdc2) and is capable of autophosphorylation and oligomerization. The activated protein binds Nek6 and RCC1, and has been shown to associate with the human homolog of the Drosophila protein Bicaudal D (Bicd2) in vivo and to phosphorylate this coiled-coil protein in vitro. NEK9 expression has been documented in normal human brain. ESTs have been isolated from several tissue libraries, including normal bone, lymph and thymus and cancerous cervix, eye, lymph and placenta.
仅用于科研。不用于诊断过程。未经明确授权不得转售。
篇参考文献 (0)
生物信息学
蛋白别名: DKFZp434D0935; MGC138306; MGC16714; NEK 9; Nek8; Nercc 1 kinase; Nercc1 kinase; Never in mitosis A-related kinase 9; NIMA (never in mitosis gene a)- related kinase 9; NimA-related kinase 8; NimA-related protein kinase 9; Serine/threonine-protein kinase Nek9; unnamed protein product
基因别名: APUG; KIAA1995; LCCS10; NC; NEK8; NEK9; NERCC; NERCC1
UniProt ID: (Human) Q8TD19
Entrez Gene ID: (Human) 91754